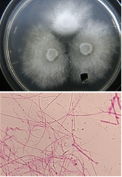

(岐阜県森林研究所) 片桐 奈々
森林のたより 2020年2月号掲載
ヒノキ根株腐朽病とは、価値が高く材積の最も大きい根元部分が腐朽する病害です(図1)。
原因は木材腐朽菌類で(図2)、これまでに複数種が判明しています。樹体内への侵入経路は、枯死根や根の傷、地際の樹幹傷(図3)といわれています。
ヒノキは罹病しても枯死はしませんが、そのまま放置すると樹体内で腐朽が拡大したり、周囲の健全木に伝播する恐れがあります。防除には、被害木の早期発見・伐採・搬出が有効と考えられます。
 |
|
 |
| 図1 ヒノキ根株腐朽病の被害 | 図2 被害木から分離した木材腐朽菌 | 図3 地際の傷から侵入した腐朽被害 |
効率良く防除を行うためには、被害地域や発生程度を把握することが重要です。そこで県内の被害発生状況を把握するため、間伐・皆伐地62林分で、根株断面の腐朽状況を調査しました。その結果、60林分で被害が確認されました。地域別の平均腐朽本数割合は最も低い東濃でも9%で、最も高い西濃では37%に達しました(図4)。特に割合の高かった揖斐と西濃の腐朽の侵入経路は、揖斐は約半分が、西濃は約4割がシカの剥皮害痕でした(図5)。
 |
 |
| 図4 地域別の平均腐朽本数割合(%)可茂、下呂地域は未調査 | 図5 シカ剥皮害痕から侵入した腐朽被害 |
今後は、未調査地域の発生状況についても把握し、被害木の早期発見に資するため、県内の全調査データをもとに、被害が発生しやすい条件(侵入経路の種類や環境、地形等)を明らかにしていきます。